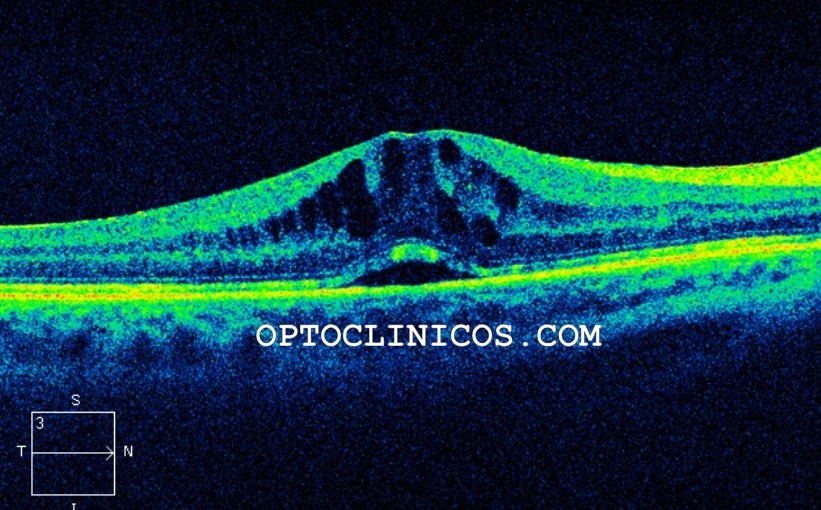
SÍNDROME DE IRVINE&nbsp;GASS

Vaya por delante que en este artículo se van a mostrar modelos de trabajo que no deben ser vinculantes para vosotros, ni la verdad absoluta, sólo una opinión, una ayuda en vuestro trabajo, para que os apoyéis y se cree un estándar actualizado que personalicéis.
Los métodos que se muestran están accesibles a través de Internet, en las páginas de calculadores. No podemos tratar las fórmulas que sean exclusivas de uso sólo con un aparato determinado, o de pago.
Son tantos los que piden a gritos sencillez que vamos a plantear cuál es el problema y cuáles pueden ser las posibles soluciones y luego ya haremos aclaraciones.
¿CUÁL ES EL PROBLEMA?
Toda la problemática con respecto al cálculo de las lentes intraoculares casi reside por completo en la famosa ELP (effective lens position), posición efectiva de la lente. Eso es lo que se intenta calcular al final del todo, ¿dónde puede quedar la lente intraocular posicionada? Por supuesto que el cálculo de la potencia es importante, pero la ELP determina el residual de la potencia calculada y gran parte del éxito de la cirugía. La ELP no puede ser medida, sino estimada.
Las fórmulas llevan evolucionando desde los años 60 y la variedad ahora mismo es abrumadora. Quizás erróneamente, en el mundo profesional, por tradición, tendencia o creencia popular, se vienen asumiendo unos supuestos con respecto a las propiedades de las fórmulas. Pero hay que romper con las clasificaciones tradicionales y tener en cuenta que existen nuevos estándares, fórmulas que tienen en cuenta la posición, la medida del cristalino, el blanco-blanco, el grosor de la córnea, la queratometría de la cara posterior antes de la cirugía, no de forma teórica estimativa, sino tomando las mediciones de los biómetros y empleándolas para sus cálculos. Lo que nos aproxima en los resultados finales, más todavía, a la lente deseada, sin tener que crear demasiadas artimañas propias. Aunque ningún aparato o fórmula nos puede dar la solución perfecta para todos los ojos y todas las lentes.
LOS APARATOS HAN CAMBIADO, LOS MÉTODOS DE MEDIDA HAN CAMBIADO, LOS RESULTADOS DEBEN MEJORAR SIN TENER QUE ANDAR CONTANDO CON LOS DEDOS:
Todos los datos obtenidos para introducir en las fórmulas ya se registran en general con biómetros modernos sean tipo OCT-SS, OCT-SA, OPD, OLCR, Scheimpflug… El empleo de la medición por ultrasonidos, de contacto, o de inmersión (mejor), quizás ya sea solamente indicación necesaria en aquellos casos en los que no es posible el registro de la medición con instrumentos ópticos, en casos de cataratas muy maduras, densas, polares y/o subcapsulares posteriores centrales, o similares.
“Es que mi biómetro saca la multifórmula con SRK-T, Hoffer Q, Holladay I y Haigis y claro, es lo que usamos”, igual que hace diez años, igual que hace quince, igual que venía en el Ocuscan o en… vamos hombre, evolucionemos, adoptemos lo que personas muy inteligentes han desarrollado y que mejora notablemente lo anterior. ¡Queremos mejorar el proceso y mejorar la mejora!
«BARRETT ES LA NUEVA SRK/T y ESCRS IOL Calculator mi página web favorita«.
Así es. Para empezar.
Id tomando como referencia a Barrett como vuestro nuevo estándar. ¿Barrett? Porque está, porque es más moderna (y mejor), porque valora en su proceso más de dos variables predictivas, cosa que SRK/T y otras no valoran. Es muy intuitiva en la introducción de datos. Las constantes de las lentes de los fabricantes se van centrando más en los cálculos de esta fórmula y junto con Kane, Evo y Hill-RBF son las que presentan mejores resultados.
Barrett Universal II tiene el menor sesgo de error en la predicción de acuerdo con las variaciones de LT (grosor del cristalino) y el efecto de omitir en la fórmula los datos de blanco-blanco (WW ó CD), es menor que el de omitir ACD o LT, pero se pueden omitir.
“Hay tantas fórmulas que no sé cuál emplear”, “mi biómetro no da la LT y entonces no valen los datos para las fórmulas nuevas”… excusas. Sí que valen, como he dicho en el párrafo anterior; hoy en día muchas ya están preparadas, porque usan métodos de regresiones lineales o inteligencia artificial, así que hacen una previsión y predicción.
«¿Para qué voy a ajustar tanto y tanta virguería si las lentes se sirven en pasos de 0.50D?» Sí, y no te olvides de que las fórmulas modernas presentan un error absoluto entorno a 0.5 D en el 80% de los casos y los márgenes de fabricación por control de calidad como poco están en +/-0.25 D, pero buscamos siempre la excelencia.
Vuestro biómetro óptico clásico ofrece Ks, ALX, ACD, la multifórmula típica: SRK-T, Hoffer Q, Holladay 1, (o 2 con suerte) y Haigis: muy bien. Qué vuestro biómetro óptico swept source / oct, más actualizado, además os ofrece LT, WW, AQD, lectura de Ks posteriores, Barrett Suite y Haigis Suite… pues eso que tenemos ganado.
El resto de las fórmulas están presentes gratuitas en Internet, ¿quién no tiene un ordenador conectado a internet en la consulta? Las fórmulas están preparadas incluso para que falten ciertos datos. Y actualmente tenemos el calculador de ESCRS que engloba un montón de fórmulas (7) que nos pueden ayudar simplemente introduciendo los datos una vez.
OS PROPONGO EL SIGUIENTE MÉTODO:
Hoy en día todos los expertos nos dicen continuamente que no tenemos que hacer aparte cinco fórmulas por cada caso que se nos presente sistemáticamente. Pero tener el calculador de ESCRS es muy útil y tentador.
Luego entonces:
Obtened una buenas mediciones con vuestro biómetro óptico: con personal con experiencia, paciente bien colocado, córneas en buen estado y ayuda de gotitas de suero si hace falta, tres, cuatro, cinco, seis, mediciones si hacen falta. Los mayores fallos y repercusiones de las mediciones en la biometría no vienen por los defectos de la medición de la ALX sino de las Ks. Repetibilidad que se llama.
Usad constantes de las lentes actualizadas en vuestros biómetros y cálculos: (pero no optimizaciones para ojos asiáticos, por ejemplo, a no ser que operéis allí, son sensiblemente diferentes). Acudid a IOL CON o a ULIB (links más abajo), o a los especialistas de producto de los fabricantes, porque las constantes pueden no estar publicadas/actualizadas en la páginas generalistas de clasificación, muchas veces es una cuestión de burocracia.
Obtened los datos biométricos y los cálculos que ya salgan con las fórmulas por defecto (multifórmula) y si podéis y la tenéis integrada en el biómetro directamente, también Barrett Universal II.
Si no os ofrece Barrett, id a Internet, ESCRS IOL Calculator, introducid todos los datos (links más adelante), saldrán muchas fórmulas que no estén incluidas en el biómetro.
CÁLCULOS EN LA PRÁCTICA:
TENÉIS UN OJO NORMAL, ENTRE 22 Y 24 MM APROX:
La multifórmula que os sale del biómetro y Barrett por contrastar. Si sale del biómetro no hemos tenido que introducir datos en la web. Y según la cte de la lente, el target de la lente, vuestra experiencia y lo que queráis conseguir de target propio para ese ojo, elegís lente.
TENÉIS UN OJO MUY LARGO A PARTIR DE 25 MM:
Obtened Barrett (donde la ACD, LT y CD tiene menor efecto en ojos largos) y si queréis también por contrastar, Kane. Aplicad el ajuste para SRK/T de Wang Koch 1 (desde 25 mm AL) o 2 (desde 27 mm).
Comparáis resultados y recordad que más vale dejar miopía residual que dejarle hipermétrope y que en estos ojos merece la pena emplear cinco minutos más. Es decir, probablemente hay que elegir una lente con residual negativo, para que no quede hipermétrope. Ya que la neutralidad a veces es una «entelequia» (puede existir o no).
TENÉIS UN OJO CORTO O MUY CORTO, MENOS DE 22 MM:
Pues la multifórmula que sale del biómetro (que esté Hoffer Q), Barrett, y la fórmula Hill-RBF para complementar.
Para ojos muy cortos (hipermétropes elevados) la mayor fuente de inducción de error en la potencia es la lectura de la ACD; verificad bien esta medida. Un error en la ACD de 0.25 mm en un ojo con una AL de 20 mm produce 0.50 D de fallo.
Considerad contrastar con Hoffer Q para AL<22 mm con ACD<2.5 mm (suele tender a un resultado un tanto miope), o con Haigis.
El artículo más reciente con ojos muy pequeños (LA 18.86-22.46 mm, LIOs entorno a 30D y mayores), da resultados estadísticos mejores con Kane, EVO, Haigis, por este orden.
En el mejor de los casos no habréis calculado nada extra en internet, o ESCRS IOL Calculator.
___
EN EL 2024, HABLEMOS UN POQUITO DE CADA FÓRMULA, NO ESTÁN TODAS:
SRK/T:
Fórmula de 3ª generación, de vergencia teórica. Basada en la longitud axial, queratometría y constante de la lente, para una predicción teórica de la ACD.
HOFFER Q:
Fórmula de 3ª generación, de vergencia teórica. Basada en la longitud axial, queratometría, una ACD teórica asociada a las diferentes longitudes axiales y a la curvatura corneal y una constante de la lente.
HOLLADAY I:
Fórmula de 4ª generación, de vergencia teórica. Basada en la longitud axial, queratometría y constante de la lente que la define como un factor del cirujano.
HOLLADAY II:
Fórmula de 4ª generación, de vergencia teórica. Basada en la longitud axial, queratometría, profundidad de la cámara anterior, espesor del cristalino, blanco-blanco horizontal, edad del paciente y una constante de la lente.
HAIGIS:
Fórmula de 3ª generación, de vergencia teórica. Basada en medición de longitud axial, queratometría, profundidad de la cámara anterior. A cada una le asigna una constante para la lente escogida, mediante un análisis de doble regresión. Podría parecer una fórmula de 4ª generación por emplear tres variables, pero en el fondo es de 3ª generación porque emplea sólo la longitud axial y la profundidad de la cámara anterior para el cálculo de la posición de la lente. Existen variantes según si se necesita cálculo para ojo normal, ojo intervenido de cirugía refractiva láser o KR, o LIOs tóricas.
BARRETT UNIVERSAL II:
Fórmula de 4ª generación, de vergencia, con tintes de 5ª generación porque ya emplea el grosor del cristalino, ACD, refracción y valor del blanco-blanco. Considerando el valor de la localización del cristalino como un factor muy relevante (ACD) y el grosor LT no siendo obligatorio. Existen variantes (hace estimación de la cara posterior de la córnea) según si se trata de ojos intervenidos de cirugía refractiva, lentes tóricas, para el recambio de LIOs o piggy back.
KANE:
Está basada en la óptica teórica e incorpora elementos de regresión y la inteligencia artificial para obtener resultados. Elaborada sobre unos treinta mil casos estudiados, revisados y filtrados mediante formulación y procesos predictivos. Parece estar más afinada en los extremos de las longitudes axiales que otras fórmulas. Existe variante para ojos con queratocono.
HILL-RBF:
Emplea patrones de reconocimiento e interpolación de datos por inteligencia artificial. Esta fórmula ha sido desarrollada con el biómetro Lenstar y con una LIO determinada, según los desarrolladores siendo válida con otros biómetros y lentes, pero obteniendo los mejores resultados en ojos hipermétropes axiales.
EVO:
Basada en la teoría de la emetropización y genera un factor emetrópico para cada ojo.
OLSEN:
Basada en el trazado de rayos, precisa una perfecta medición de la cámara anterior y del grosor del cristalino para el cálculo final de la LIO. Emplea la longitud axial, la queratometría, la profundidad de la cámara anterior, espesor del cristalino, refracción preoperatoria y una constante para la lente. Desarrollada con el biómetro Lenstar y ya incorporada en otros biómetros.
KARMONA:
Del gran profesional, investigador y optometrista español Dr. David Carmona. Con base en inteligencia artificial. Devuelve predicción de la potencia refractiva de la lente emetropizante, no la ELP.
PEARL-DGS:
Basada en IA, con acceso más sencillo a través de ESCRS.
ADEMÁS DE FÓRMULAS HAY AJUSTES PARA MEJORAR LAS FÓRMULAS EN MIOPES ALTOS AXIALES:
AJUSTE DE WANG-KOCH (y ajuste corregido de Wang-Koch):
Cálculo de ajuste que se emplea para longitudes axiales a partir de 25 mm aprox, para aplicar a las fórmulas de SRK/T y a Holladay I y Haigis (cada una con sus propios coeficientes). Estos ajustes no son útiles en otras porque ellas mismas hacen reajustes propios. Aquí sólo vamos a hablar de SRK/T como referencia de fórmula de tercera generación y vamos a comparar los resultados con Barrett y Kane más adelante.
AJUSTE DE WANG-KOCH SRK/T PARA OJOS DE 25.2 HASTA 27 MM:
AL = (0.854 X IOLM AL) + 3.72
(la longitud axial corregida es igual a 0.854 multiplicado por
la longitud axial del IOL Master más 3.72)
AJUSTE DE WANG-KOCH CORREGIDO SRK/T PARA OJOS A PARTIR DE 27 MM:
AL = (0.8453 X IOLM AL) + 4.0773
(la longitud axial corregida es igual a 0.854 multiplicado por
la longitud axial del IOL Master más 3.72)
Se sustituye esta AL obtenida por la ya medida en el biómetro o en la fórmula de SRK/T en internet o en el biómetro y obtendremos un valor de LIO compensada, pero ojo: para SRK/T.
___
POSIBLE ESPECTRO DE USO DE LAS FÓRMULAS ACTUALES SEGÚN LA LONGITUD AXIAL.

___
COMPARAMOS SRK-T, SRK-T CON AJUSTE WK, BARRETT Y KANE PARA OJOS NORMALES Y GRANDES (QUE SON MÁS ABUNDANTES QUE LOS PEQUEÑOS).

Esto es: SRK/T falla estrepitosamente en el extremo negativo, y veis que la SRK/T con WK , Barrett y Kane se aproximan todas más, obteniendo una LIO más acorde con la realidad del resultado tras la implantación.
Antes se podía hacer la cuenta –basada en errores por experiencias- de (por ejemplo): “de la SRK/T para la lente del ojo de 31 mm de ALX subo tres pasos, tres lentes y aproximadamente esa es la que pongo”. Ahora Barrett, Kane o los ajustes de la SRK/T WK ya me están dando casi eso sin tener que estimarlo, sólo microajustando.
___
EFECTO DE LOS CAMBIOS EN EL TAMAÑO DEL CRISTALINO Y POSICIÓN PARA SRK/T Y BARRETT.

A la fórmula SRK/T le da igual dónde se sitúe y qué grosor tenga el cristalino, ¡da siempre el mismo resultado! Pero es muy importante para el cálculo final de la lente. Barrett sí lo considera, pudiendo ser la LIO elegida diferente de SRK/T y más acertada. En las tablas no he incluido el residual teórico de la LIO elegida, que para esta cte (como podéis ver haciendo la resta entre la LIO neutra y la elegida) hemos escogido entre neutro y leve negativo para Barrett, pero para SRK/T sería mucho más negativo (lente más potente) lo que nos guiaría, si sólo nos fijásemos en SRK/T, hacía una LIO menos potente y en algún supuesto, errónea.

___
LOS TRUCOS DE CADA UNO:
Hay conferencias enteras sobre estas cosas, y grandes expertos que han ido creando sus nomogramas según las lentes con las que trabajan. Os relato inicios de algunas perlas, comunes unas y rebuscadas otras, sólo para pensar en ello:
– Hay gente que hace media de las fórmulas y entonces escoge la LIO.
– Hay gente que cuantas más fórmulas emplea, más dudas tiene.
– Cuando analices un caso post cirugía refractiva, obtén todos los datos que puedas o los más aproximados. Todos. K previa (K anteriores y posteriores, TK), K postoperatoria, paquimetría previa y postop, Rx previa y postop, etc. Luego ya tendrás tiempo de desecharlos si no los usas, o de elaborar diversos supuestos.
– Cuando calcules una LIO tórica no lo hagas sólo con la fórmula del fabricante de la LIO, aplica otra al menos, por ejemplo Barrett Universal II Toric.
– Obviando todas las variables que afectan, cuando una LIO tiene una tendencia, (por ejemplo: siempre sale negativa o positiva y siempre tengo que escoger la primera negativa o positiva para que me quede en mi target deseado -negativo, neutro, el que sea-) hay profesionales que ajustan la constante de la lente; así tras el cálculo les sale el resultado de la LIO como ellos quieren verla, ya la lista de potencias les muestra una aproximada a lo que quieren ver. Experiencia, repetibilidad, registro minucioso de los ojos operados, un solo usuario, o exactos protocolos de cirugías. Pero, NO optimicéis una LIO en un biómetro con datos propios si lo usan otros (…). Lo normal es que te apuntes cuál es la tendencia y escojas siempre el resultado que te conviene, si compartes biómetro y no quieres complicarte la vida a ti y a otros. Como mucho si te arrojas a hacer una optimización, pon esa lente con tu nombre en el biómetro “SWM90 optimizada optoclínicos”, por ejemplo.
– Cuando un fabricante te dice que escojas la primera LIO negativa (o positiva) que sale en el cálculo es porque han demostrado en las evaluaciones clínicas que con esa constante y esa elección de residual todos los resultados deseados están más cerca del target adecuado de enfoque, escogiendo esa que os sugieren; muchas veces NO es porque no quieran optimizar ellos la constante más allá, sino que esa lente por su construcción, NECESITA ese resultado para que funcione en el mejor rendimiento (la famosa curva de desenfoque). No todas las lentes precisan un resultado neutro en el ojo.
– Cuando hay una ACD+LT que supera los 7 mm se suele buscar una potencia un poco mayor para la LIO porque la posición efectiva de la LIO resultará un poco más atrás, pero las fórmulas nuevas valoran esto. Y hay que considerar también si tenemos Ks muy potentes (que pueden no necesitar incremento de la potencia de la lente) o Ks planas (que pueden requerir incremento en la potencia final de la lente).
-Si hay un saco muy grande, la lente se puede venir solita un poquito más adelante (la ELP cambia de la teoría a la práctica), dando un resultado más negativo de lo deseado, o a veces un libre albedrío. Poe eso es muy bueno conocer el valor de LT y emplearlo. Quizás, pensando como un jefe de obra, a lo mejor hay que plantearse un anillo capsular para tensar un saco grande y que la LIO no baile –hay cirujanos que lo hacen por sistema y la verdad es que se aproximan mucho más a los resultados teóricos porque las fórmulas calculan para que la LIO esté en mitad del espacio que antes ocupaba el cristalino.
– Si una lente está al revés tenderá a dar un resultado mucho más negativo del deseado, si las patas tienen angulación, obviamente. Aparte de la probable pérdida de sensibilidad al contraste y artefactos, si es alguna clase de multifocal o Edof, por haber volteado la cara de los anillos difractivos o áreas refractivas.
– Si se hace un piggy back con una ADD ON, una LIO tipo Artisan tras pupila, una ICL o Eyecryl Phakic, IPCL, o una LIO pinhole, delante de una lente en saco, es posible que esta vaya un poco hacia atrás, quedando el paciente un poco hipermétrope.
– En los cálculos las incisiones tienen efecto, tanto sobre LIOs tóricas como sobre esféricas, a no ser que tengas el SIA muy neutralizado. Quien hace los cálculos sugerirá una localización de incisiones, que si no coinciden con las que se realizan en la práctica producirán cilindros o esferas residuales inducidos no previstos. Una incisión suele relajar su meridiano e incurva el otro y una sutura suele incurvar su mediano y aplana otro. Al igual que si el efecto de la incisión está previsto para una microincisión y acabas entrando con 3.2 mm…adiós cálculos.
– Si tu biómetro lee la TK (Total Keratometry = ha leído la cara posterior, la anterior y considera el espesor corneal), esto nos permite verificar el efecto del astigmatismo de cara posterior en casos particulares, por ejemplo. Es mucho más importante el uso de la TK en ojos con cirugía corneal láser. En algunos biómetros se puede combinar la Total Keratometry con fórmulas como la Barrett True K, o Haigis post cirugía refractiva. En general en estos biómetros se puede combinar el uso de TK con casi cualquier fórmula, pero repito que la diferencia es mucho más importante en los ojos intervenidos con excímer.
– Cuando una LIO tiene que ir a sulcus, NO es la misma potencia de la lente en saco menos 0.50 siempre. Depende de la potencia de la lente de partida (hay que disminuir un 5% aproximadamente la potencia para sulcus) y por supuesto de la cte: puede ser -0.50, -1.00, -1.50… hay tablas. (Link más adelante o la tabla que os pongo). Se calcula la LIO para saco y se hace el ajuste para sulcus según esas tablas.

Y cuantísimas observaciones y trucos habrá más. Pero hay que ir de lo fácil a lo difícil.
___
Links de interés:
Listado con la mayor parte de las lentes intraoculares del mundo, con las constantes más actualizadas y fotografías de las lentes:
https://iolcon.org/lensesTable.php
Listado de lentes intraoculares ULIB:
Tabla para recálculo de LIO en sulcus:
https://www.facoelche.com/utilidades/conversion-de-potencia-de-lios-saco-sulcus/
Algunos enlaces a fórmulas para cálculo de LIOs:
ESCRS IOL Calculator: 7 fórmulas de última generación a tu servicio.
https://iolcalculator.escrs.org
Fórmula Barrett Universal:
https://calc.apacrs.org/barrett_universal2105/
Fórmula Barrett Universal Tórica:
https://ascrs.org/tools/barrett-toric-calculator
Calculador SRK-T, Holladay I, Hoffer Q y Haigis.
http://www.eyecalcs.com/WEBCALCS/IOLcalc/IOL.html
Fórmula Kane:
Fórmula Hill-RBF:
https://rbfcalculator.com/online/index.html
Fórmula EVO:
https://www.evoiolcalculator.com/
Fórmula postlasik, post PRK, post KR:
Fórmula Barrett para calcular explante y reimplante:
https://ascrs.org/tools/barrett-rx-formula
Fórmula Barrett para postlasik y KR:
http://calc.apacrs.org/TrueKToric105/truektoric.aspx
Espero, humildemente, que os haya sido de alguna utilidad el artículo.
Jesús Pizarroso Pulido.

























 En este tipo de profesiones en las que tenemos que lidiar con pacientes –público al fin y al cabo-, y profesionales de diversas especialidades, hay que ejercer un acto de contención continuado y de habilidad para comunicarse a ciertos y diversos niveles.
En este tipo de profesiones en las que tenemos que lidiar con pacientes –público al fin y al cabo-, y profesionales de diversas especialidades, hay que ejercer un acto de contención continuado y de habilidad para comunicarse a ciertos y diversos niveles.